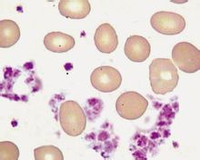
血小板

區別對比
 MPV車型
MPV車型MPV同小型麵包車存在明顯的區別。麵包車是單廂式結構,即乘客空間和發動機共同在一個框架結構內,發動機被安放在駕駛員座位的後下方。採用這種布局,車體結構簡單,但是整車高度相對增加,同時車內空間增加,發動機噪音相對較大。並且由於前排座椅處在全車的最前面,在發生正面撞擊事故時駕駛員及前排乘客前方的緩衝空間很小,所以安全係數較低。
現在的MPV首先是要具備兩廂式結構,布局以轎車結構為基礎,一般直接採用轎車的底盤、發動機,因而具有和轎車相近的外形和同樣的駕駛感、乘坐舒適感。由於車身最前方是發動機艙,可以有效地緩衝來自正前方的撞擊,保護前排乘員的安全。許多MPV都是在轎車平台上生產出來的,福田蒙派克採用的就是源自賓士唯雅諾第三代MPV底盤技術,此外像風行菱智的原型車則為三菱太空艙,它的車型設計更加成熟可靠。
MPV擁有一個完整寬大乘員空間,這使它在內部結構上具有很大的靈活性,這也是MPV最具吸引力的地方。車廂內可以布置下7-8個人的座位,還有一定的行李空間;座椅布置靈活,可全部摺疊或放倒,有些還可以前後左右移動甚至鏇轉。放倒第三排座椅,就像是一輛具有超大行李空間的臥車;右邊三張座椅同時放倒,就擁有一個超長載貨空間;第二排座椅向後轉180°,可以和第三排面對面相坐交談,又或者把靠背前折,椅背就是桌面,辦公娛樂,隨便你怎樣安排,在這方面做得比較好的就是福田的蒙派克,空間比同類車型足足大出1.3m³。
車型數據
10日,中國汽車工業協會公布了11月的汽車市場產銷情況。數據顯示,11月,在乘用車主要品種中,四大類品種環比均呈一定增長,而與上年同期相比,多功能乘用車MPV產銷依舊呈現下降,交叉型乘用車產量微增,銷量有所下降,其它品種保持增長。
11月,基本型乘用車轎車產銷99.43萬輛和103.28萬輛,環比增長10.79%和14.10%,同比增長5.43%和11.33%;多功能乘用車MPV產銷4.07萬輛和4.27萬輛,環比增長2.40%和2.51%,同比下降14.07%和8.56%;運動型多用途乘用車SUV產銷17.92萬輛和18.92萬輛,環比增長13.07%和15.23%,同比增長6.26%和18.02%;交叉型乘用車產銷21.78萬輛和19.66萬輛,環比增長18.08%和4.62%,產量同比增長1.28%,銷量下降5.90%。
1-11月,基本型乘用車轎車產銷978.85萬和974.70萬輛,同比增長6.46%和6.24%;多功能乘用車MPV產銷45.40萬輛和45.22萬輛,同比下降2.87%和0.17%;運動型多用途乘用車SUV產銷180.06萬輛和179.33萬輛,同比增長25.05%和26.26%;交叉型乘用車產銷203.82萬輛和203.99萬輛,產量同比增長0.85%,銷量下降0.78%。
MPV簡史
MPV概念車型最早由克萊斯勒創造。30年前,克萊斯勒汽車集團創造了一個前所未有的車型概念——“minivans”,意為廂式旅行車,實際上就是“轎車加卡車”、“舒適加承載”的設計理念,隨後國際市場將此類車型發揚光大並統稱為“MPV”。2012年11月28日,這款已擁有78項行業第一、榮獲過260項國際大獎、全球銷售累計超過1,300萬台的克萊斯勒品牌重磅產品,重返中國豪華商務MPV車型市場。全新進口大捷龍的推出,不僅給目前略顯單調國內高端豪華商務MPV市場在提供了一個新選擇,也標誌著克萊斯勒品牌繼續在中國豐富其產品的決心。
 MPV車型
MPV車型MPV是適合各類用戶使用的多功能車。公司可用於中短途商務旅行,職工交通車。MPV更適合家庭使用,平時上下班,周末購物,假日裡全家大小親朋好友一起到郊外旅行,一輛MPV就可以輕鬆應付。MPV的實用性、舒適性、安全性,將使它日漸成為人們的新寵。
十幾年前剛剛在中國出現時被稱為“子彈頭”的雪佛蘭魯米娜、前幾年的豐田大霸王;現在的上海通用別克GL、寶駿730、福田蒙派克、風行菱智、金杯閣瑞斯、上海大眾途安、廣本奧德賽、東風悅達起亞的嘉華、海馬的普力馬、東南的菱紳、江淮的瑞風、奇瑞的東方之子Cross,也就是現在的威麟V5,東風雪鐵龍的畢卡索、豐田Alphard、豐田的普瑞維亞(PREVIA),東風鄭州日產的帥客等都算是MPV車。其實畢卡索更應算是單廂式轎車,而非一般意義上的MPV,這是因為畢卡索空間相對較小,只能乘坐5個人。而一般來說MPV的乘員應在7-8人左右。隨著MPV之風越刮越烈,更多企業也想將自己的產品列入MPV的陣營里,因此,MPV的概念也越來越含混,復蓋面漸漸擴大。這主要表現在輕型客車、單廂轎車與MPV的界定上;如7座、9座的金杯海獅、東南得利卡等客車,利華的幸福使者、長安之星之類的微型客車是否被稱為MPV就更值得商榷了。
車型名單
B
賓士:賓士R級、威霆、唯雅諾、Sprinter
比亞迪:M6 、e6、商
本田:奧德賽、艾力紳、傑德
別克:GL8
標緻:807 、5008
北汽威旺:M20
上汽通用五菱:寶駿730
寶馬:2系Gran Tourer
C
長安:傑勛
長城:騰翼V80、嘉譽
長豐:騏菱、長安歐諾
D
東風:御風
東風風行:菱智、帥客
東風風度:御軒
東風小康:風光330、風光360
大眾:途安、開迪、夏朗、邁特威、凱路威
道奇:凱領
帝豪:EV8
F
菲亞特:多寶
豐田:Wish、埃爾法、逸致、普瑞維亞、Sienna
福特:C-MAX、S-MAX、全順
福田:蒙派克
G
GMC:Savana
H
哈飛:陸尊大霸王
海馬:普力馬
J
吉利:全球鷹GV5
江淮:瑞風、瑞風M5、和悅RS
金杯:大海獅、閣瑞斯
K
開瑞:優派、優勝、優雅、優優、優翼
克萊斯勒:大捷龍
L
雷諾:風景
鈴木:浪迪
陸風:風尚
M
馬自達:馬自達5、馬自達8
N
納智捷:大7、MASTER CEO
南京依維柯:寶迪、得意、都靈
O
歐寶:麥瑞納、賽飛利
Q
奇瑞:東方之子Cross、艾瑞澤M7
起亞:嘉華、VQ、佳樂
R
日產:駿逸、貴士、NV200
S
三菱:格藍迪、君閣、菱紳
雙龍:路帝
W
威麟:H3、H5、V5、V8
五菱 :五菱之光、五菱宏光、五菱宏光S、征程
X
現代:H-1輝翼、美佳
雪鐵龍:DS5、畢卡索
雪佛蘭:Orlando
Z
眾泰:M300、朗悅
誕生年代
在美國許多青年人特別鍾愛日本小轎車,或許是因為它比美式大轎車更精緻、經濟、實用。但是幾年後他們成家立業有了孩子,原來又比較寬敞的日本小車就顯得有些侷促了。美國人天性喜歡長途旅行,夏天帶著妻子、兒女,還有自己的寵物、行李,離開城市到環境優美的鄉村度假。當時的旅行車早已出現,但貌不驚人,若強調其實用性、舒適性、安全性這幾項綜合性能,它就不太理想了,在這種形勢之下,MPV的流行看起來是十分合理的了。
“多用途車”MPV的特點
儘管MPV的車身重新設計,擁有獨一無二的子彈頭風格,但方正的車身還是能夠叫你想起單廂麵包車。但是為什麼它會如此受人歡迎呢?
結構基礎
 MPV
MPV一般采轎車底盤,因而它具有接近轎車的舒適感受。其發動機的裝置打破了單廂麵包車的發動機都裝在車廂內這個特點,而將發動機橫置裝在車頭內,因而可以緩衝來自前方的碰撞從而提高前排乘員的安全。
MPV的單廂式車身設計
車廂內可以布置下8個人的座位,還有一定的行李空間,所以非常適合一家人外出長途旅行。車廂內的座椅布置靈活,可全部摺疊放倒或部分摺疊,像菱智1.6L的座椅就有9種組合方式,這無疑給人們提供了更大的便利和載貨空間,可以為假日外出購物服務。MPV的車身設計還融入了低風阻流線型的賽車風格,因而具有賽車的享受,叫人興奮不已的子彈頭外觀更讓人感到無比的刺激。
流行市場
引得世界各國競相研製MPV車,其中有美國的道奇卡拉旺和順風的航海家,還有福特風之星和雪佛蘭魯米娜等。在歐洲雷諾也推出性能優越的ESPACE太空車,以其優良的操作性和多樣化的遊樂功能而傲視群雄,在全歐占近半數的份額,其還擁有一款頂級MPV太空車——BITURBO QUADRA,配備A610賽車發動機,堪稱MPV中的法拉利。歐洲的其他公司躍躍欲試,德國大眾與福特共同開發的MPV即將推向市場,還有義大利菲亞特、法國雪鐵龍-標緻也要共同開發MPV,並將形成一定的生產規模。在亞洲的日本有豐田的大霸王等。廣東湛江三星公司已數次進口組裝了2000多輛日本MPV,而風行菱智車型則從三菱太空艙而來,底盤系統源自全球知名的三菱帕傑羅底盤,具有高剛性和耐用的越野底盤特質,沿襲了日系車過硬的整體質量,成為一款經典MPV車型。如今德國梅賽德斯賓士又將與中國南方汽車公司合作生產MPV,並將形成6萬多輛的年生產規模。
購買力
1~6月全國MPV市場累積銷售10.2萬輛,較去年同期相比增長22.07%。其中高端市場的增長率為44.09%,中端市場為25.42%,低端市場為20.56%。這組數據顯示,MPV的增長速度與地方經濟有明顯的對應關係,與轎車市場在大城市增長率放緩的情況相反。
在大排量、中高排量、中排量和小排量四個分組中,大排量增幅最大,達到56.17%,中高排量為24.26%,中排量為39.45%,小排量為-5.74%。大排量在高端市場的增長率為125.12%,中端市場為61.54%,低端市場為24.04%。而小排量在高端市場的增長率為7.38%,中端市場為-8.1%,低端市場為-7.33%。
根據豐田的研究,從汽車發展歷史的角度看,汽車市場發展初期,首先在市場上處於高速增長的是高價格、大排量的車,其後才是小排量、低價格的車。從這個意義上說,中國的MPV市場仍處於初級階段。
據介紹,這份報告分為公共部分和個性化部分兩部分,從公共部分的報告看,今年上半年市場總體運行情況與去年的情況變化不大,只是在一個更高的水平上運行。而個性化部分則展示出各企業在不同細分市場的競爭態勢,呈現出此消彼長的狀況,並可以看出企業在區域市場上的發展趨勢,以及未來最有希望的區域。
全能MPV
近年來,在基層MPV市場出現了消費者偏愛正統MPV的趨勢,高端微客和CDV車型以其經濟的價位和排量,以及較之傳統微客更具商務味道的設計,成為這一市場的熱銷車型。但實際上,高端微客和CDV車型遠不是真正意義上的“MPV”。
傳統的MPV排量大,價位高,無法吸引注重經濟和實用性的縣、鄉(鎮)及縣屬的基層政府、事業單位、個體商戶和私營業主為主體的基層公商務MPV用戶。基層公商務MPV用戶對正統小排量大空間MPV的熱情逐漸增高,它具有的油耗小、價位低等特點吸引了大批用戶,以風行菱智1.6L為代表的正統小排量大空間全能MPV的熱銷,也預示著它們的春天已經到來。
菱智1.6L是國內首款小排量、大空間全能商務車,定位在6-8萬級別市場,上游承接MPV市場的下移,中間分化輕客市場和CDV市場的平移,下游迎接大微客的升級,合理的定位形成了一個新的細分市場——6-8萬元多功能商務車市場。它誕生自國際化MPV平台,原車型為日本三菱SPACE GEAR L400太空車,它集寬敞的室內空間和優良的功能於一身,兼顧轎車舒適的乘坐感覺及超群的操縱穩定性,體現出人性化設計理念,在商務形象、駕乘舒適、使用空間等方面均遙遙領先相同價格帶的其它車型。這一居高臨下的優越血統,決定了菱智1.6L在小排量商務車市場無可比擬的領跑者地位。憑藉正宗的MPV血統和極具親和力的定價,菱智1.6L也成為了個體老闆、私營業主等商務群體和縣鄉(鎮)級政府單位和事業單位等公務群體購買商務車的“黃金之選”。菱智1.6L於2011年10月份底在廣州、鄭州、上海、山東區域進行試銷,12月份銷量就突破了4000台,成為小排量MPV市場中最受歡迎的車型,成功破局商務車市場。2012年2月份,該車已在全國全面上市。
菱智1.6L的熱銷必將帶動更多車企進入這一細分市場,而以菱智1.6L為代表的小排量大空間全能商務車的崛起,預示著小排量大空間全能的商務用車將成為MPV市場的一個新增長點,同時也將終結小排量MPV市場的“用車尷尬”,MPV市場也向著高性價比、高普及度的方向健康發展。
選購標準
1、外觀是否大氣;
2、空間是否寬敞;
3、駕乘是否舒適;
4、油耗高低,使用成本高低;
5、動力是否可靠;
6、安全性能是否可靠。
其它名詞
multy purpose vessel或者multi-purpose vessel.
血小板
血小板MPV多用途貨船 一般可以拉散貨,也可以貨櫃\鋼材等非散貨,可裝載貨櫃,包裝貨,以及鋼卷板等。一般有大吊,50噸以上,很多的有可移動的2層甲板,有可移動的橫艙壁,和貨櫃船比較相似,充分體現了多用途性。
平均血小板體積(MPV)Meanplateletvolume 用於判斷出血傾向及骨髓造血功能變化,以及某些疾病的診斷治療。MPV減少可見於脾亢、化療後、再障、巨幼細胞性貧血等。骨髓造血功能衰竭時。MPV與PLT(血小板)同時持續下降;造血功能抑制越嚴重,MPV越小。
五種車型
大型多功能休旅車(Large MPV)-車長超過4,600mm,乘坐人數多在七人以上,座椅配置採用三排。有些大型MPV會被認為是Van箱型車。在大陸型國家,因國土幅員遼闊,加上居民人高馬大,在美國上市的MPV大多屬於這一級,因此他們直接稱之為“minivan”。
緊湊型多功能休旅車(Compact MPV)-的車身長介於4,200mm至4,600mm之間,乘坐人數為6~7人,座椅配置採用三排(222或232),多採用前兩排標準座位,第三排則為補助座位。
中型多功能休旅車(Middle MPV)-介於緊湊型和小型之間,車身長大約介於4,100mm至4,200mm之間,乘坐人數為5~6人,座椅配置採用兩排。
小型多功能休旅車(Mini MPV)-大約在2000年左右開始在市場上蔚成氣候,其車長短於4,100mm,乘坐人數為5人以下,座椅配置採用兩排。
迷你型多功能休旅車(Microvan)-比起傳統掀背車,迷你型多功能休旅車刻意加大車高。

